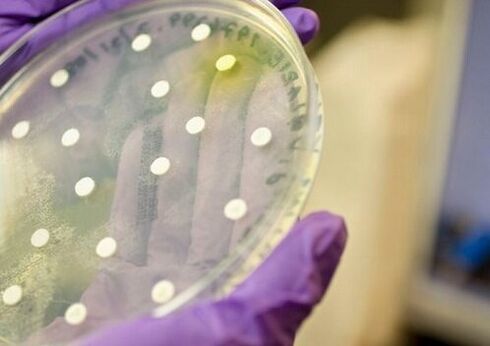
Coltura batterica per la diagnosi di prostatite

La prostatite negli uomini è una malattia infiammatoria comune che, se non trattata, provoca cambiamenti irreversibili nei tessuti della ghiandola prostatica. La forma cronica della malattia non presenta sintomi chiari, ma possono comparire durante l'esacerbazione della patologia. I sintomi e il trattamento dipendono in gran parte dalla gravità della malattia e dal coinvolgimento di altri organi del sistema genito-urinario nel processo infiammatorio.

Un urologo deve fare una diagnosi, determinare la forma della malattia e prescrivere un trattamento.
Segni di prostatite acuta
La prostatite acuta presenta sintomi simili in diverse forme. Può essere catarrale, parenchimale, follicolare e ascessiva. Con lo sviluppo dell'infiammazione acuta della prostata, le condizioni generali di salute peggiorano abbastanza rapidamente. I primi segni di prostatite negli uomini sono caratterizzati dalla comparsa di dolore nella zona inguinale. La temperatura corporea può raggiungere i 40 gradi. Durante questo periodo, il paziente avverte brividi, mal di testa e debolezza muscolare.
Si osserva un leggero sollievo dalla condizione e una diminuzione del disagio quando un uomo giace sulla schiena e preme le ginocchia sullo stomaco.
Molti pazienti con prostatite acuta notano dolore nel retto, alcuni di loro si sentono come se ci fosse un oggetto estraneo al suo interno. Una prostata infiammata può manifestarsi anche come problemi con i movimenti intestinali.

La prostatite acuta può essere accompagnata da sintomi simili alle infezioni intestinali e alle malattie infiammatorie del basso intestino.
Ciò si spiega con l’ingrossamento della ghiandola prostatica dovuto all’infiammazione e al crescente gonfiore dei suoi tessuti, che esercitano pressione sull’intestino. Pertanto, i sintomi della prostatite acuta si manifestano talvolta con ritenzione di feci, flatulenza e falso bisogno di defecare.
In alcuni casi, i pazienti avvertono forti dolori durante i movimenti intestinali. La manifestazione della malattia è possibile anche con un aumento delle sensazioni spiacevoli nella regione centrale dell'addome. Spesso, la prostatite acuta può presentare sintomi come secrezione dall'ano sotto forma di muco, che è associata alla comparsa di infiammazione nel retto stesso. Poiché la prostatite acuta molto spesso presenta sintomi associati al coinvolgimento dell'intestino nel processo patologico, a volte non è possibile eseguire la palpazione rettale a causa del forte dolore al retto.
I primi sintomi della prostatite acuta possono sembrare un'infiammazione delle vie urinarie. Prima che un problema alla prostata diventi evidente, può svilupparsi difficoltà nello svuotamento della vescica.

Problemi con la minzione di vario tipo accompagnano quasi sempre la prostatite acuta.
Un uomo può sentire pressione al suo interno, così come una sensazione di svuotamento incompleto. Il flusso di urina durante l'infiammazione della ghiandola prostatica è spesso indebolito. Alcuni pazienti lamentano una completa incapacità di urinare. Tali sintomi di prostatite negli uomini indicano la necessità di un intervento medico rapido, poiché con la ritenzione urinaria acuta aumenta l'intossicazione, che si manifesta con forti mal di testa, mancanza di appetito, vomito e ittero della pelle. Questa condizione è pericolosa e richiede il ricovero immediato.
Segni di prostatite cronica
I problemi cronici alla prostata non sono sempre chiaramente manifestati; i sintomi possono essere così inespressi che gli uomini attribuiscono la comparsa di stanchezza e debolezza ad altre circostanze. Il paziente molto spesso apprende che esiste una tale malattia durante una visita medica o quando visita un medico per un'altra malattia.

Spesso la prostatite cronica accompagna altre malattie genito-urinarie, per le quali il paziente consulta un medico.
Quali sintomi sono caratteristici dell'infiammazione cronica della prostata? Si tratta di disagio e sensazione di pesantezza al perineo, bruciore e pressione nell'uretra durante lo svuotamento della vescica. Possono comparire secrezioni dal canale uretrale e fili purulenti nelle urine. Tali segni e sintomi dovrebbero avvisarti ed essere un motivo per visitare un urologo.
Molto spesso le malattie croniche delle ghiandole sono accompagnate da problemi nella zona intima.
La prostatite può causare eiaculazione accelerata, orgasmi lenti e diminuzione della potenza. A volte un uomo perde completamente interesse per il rapporto sessuale, diventa più aggressivo e sviluppa depressione. Alcuni pazienti soffrono di insonnia e stanchezza generale. Compaiono anche paure legate all'attività sessuale e ai fallimenti durante i rapporti sessuali, che a volte portano all'esaurimento nervoso. Anche il suo trattamento è necessario, quindi in alcune situazioni il medico curante può indirizzare il paziente a un consulto con uno psicoterapeuta.

Lo stress nervoso costante riduce l'immunità, il che peggiora ulteriormente il decorso della malattia.
Misure terapeutiche
Prima di trattare la prostatite, l'urologo prescrive un esame al paziente. Un uomo deve donare il sangue per i livelli di PSA, ferro e un test generale delle urine. Anche il succo della prostata è soggetto ad esame.
È impossibile curare la prostatite da soli. Alcuni uomini cercano di migliorare le condizioni della ghiandola ricorrendo a metodi non convenzionali o popolari che possono ridurre i sintomi della malattia. Di norma, la prostatite peggiora e, senza ulteriore trattamento, la malattia porta a complicazioni: indurimento del tessuto ghiandolare, disturbi della minzione e perdita della funzione riproduttiva.
Il trattamento prescritto nella fase iniziale della prostatite è molto più efficace. Un rapido miglioramento delle condizioni del paziente è facilitato da un approccio esclusivamente globale.

È importante consultare tempestivamente un medico per prescrivere un trattamento.
Grande importanza viene data alle ragioni che hanno causato la disfunzione della prostata. Se non vengono identificati i fattori provocatori, la probabilità di ricaduta della malattia è molto alta.
L'urologo seleziona i tipi di trattamento a seconda della forma e dello stadio della prostatite. Il medico tiene conto della presenza di malattie concomitanti, alcune delle quali possono diventare una controindicazione alla prescrizione di determinati farmaci al paziente.
Per la prostatite batterica
La base della terapia per la forma acuta della malattia sono gli agenti antibatterici. È molto importante che il paziente rimanga a letto durante il trattamento. Con questo tipo di prostatite non bisogna massaggiare in nessun caso la ghiandola prostatica. Anche la raccolta del succo prostatico in questo modo è vietata. Ciò è dovuto all'elevata probabilità di complicanze settiche.

In caso di infiammazione acuta della prostata causata da infezione è necessario limitare il più possibile l'attività fisica.
Per la prostatite batterica sono indicati agenti per migliorare la microcircolazione nei tessuti della ghiandola.
L'efficacia dei farmaci è dovuta al fatto che ripristinano il deflusso del liquido linfatico e del sangue dalla prostata, contribuendo a ridurre i sintomi di intossicazione.
Poiché la prostatite batterica è quasi sempre accompagnata da dolore acuto, ai pazienti vengono prescritti NRVS e analgesici che riducono il disagio e la pressione sia nel perineo che nel retto. Ai pazienti vengono mostrati farmaci analgesici che non solo riducono il dolore, ma aiutano anche a ridurre la gravità del processo infiammatorio.
Le supposte rettali hanno un buon effetto, funzionano in modo abbastanza efficace grazie alla vicinanza del retto e della prostata. Le supposte possono contenere ingredienti naturali, ad esempio miele, propoli, estratto di prostata bovina. Tutti questi componenti sono sicuri, ma allo stesso tempo molto efficaci.
In caso di intossicazione significativa, le soluzioni vengono somministrate ai pazienti. Se l'esame rivela un ascesso prostatico o il paziente presenta ritenzione urinaria, è indicato il trattamento chirurgico.
La terapia della prostatite batterica si basa sull'uso di farmaci antibatterici appartenenti al gruppo dei fluorochinoloni. Questo tipo di medicinale è efficace nell'attivare la flora patogena gram-negativa.
Per la prescrizione più accurata del trattamento, è necessario eseguire un test colturale per la sensibilità agli antibiotici.
I medici affermano che tali farmaci dovrebbero essere prescritti solo dopo aver identificato il tipo di microrganismi che hanno causato la malattia della prostata. I fluorochinoloni possono causare effetti collaterali se il paziente ha disfunzione epatica o renale. A volte i pazienti sviluppano cambiamenti nel tratto digestivo e nel sistema nervoso. Possibile diminuzione della glicemia, problemi cardiaci.
Se vengono identificati microrganismi patogeni insensibili ai fluorochinoloni, al paziente vengono prescritti macrolidi o cefalosporine. Questi farmaci sono indicati anche quando il paziente manifesta effetti collaterali derivanti da farmaci precedenti. Se dopo due settimane non si riscontra alcun miglioramento, l’urologo dovrà riconsiderare il regime terapeutico.
Per malattie croniche
I metodi terapeutici della prostatite cronica dipendono in gran parte dal suo stadio. In caso di esacerbazione della malattia, il trattamento viene effettuato esattamente allo stesso modo della forma batterica acuta.

Per la prostatite cronica, gli antibiotici vengono spesso prescritti sotto forma di compresse.
Per i sintomi caratteristici di uno stato di remissione, possono essere indicati antibiotici, antisettici a base di erbe, non steroidi e farmaci che aiutano a migliorare il deflusso della linfa dalla ghiandola.
Grande importanza viene data anche ai farmaci che aiutano a migliorare la funzione del sistema immunitario. I preparati naturali a base di erbe aiutano a ridurre il gonfiore del tessuto prostatico. Questi stessi farmaci riducono il dolore, che talvolta è presente nella prostatite cronica.
Poiché la malattia è spesso accompagnata da depressione e nervosismo, al paziente possono essere prescritti sedativi e antidepressivi.
La terapia fisica ha un buon effetto. Esercizi speciali aiutano a ripristinare l'afflusso di sangue alla ghiandola, ad aumentare il tono muscolare e a migliorare l'umore.

È meglio condurre le lezioni di terapia fisica sotto la guida di un allenatore con una formazione medica.
Come misure aggiuntive, i pazienti vengono sottoposti a un ciclo di procedure fisioterapeutiche che ripristinano la microcircolazione, alleviano la tensione nella zona pelvica e alleviano il dolore. La terapia laser, l'elettroforesi e il trattamento con i magneti hanno un buon effetto.
Il massaggio eseguito per via rettale ha un effetto positivo sulla salute della prostata. Questa procedura può essere eseguita sia in clinica che a casa. Se tale trattamento viene prescritto per la prima volta, è meglio eseguire il primo corso con un professionista. Il massaggio è molto efficace per la congestione della ghiandola. Il massaggio prostatico può provocare qualche disagio, ma solo nei primi giorni di trattamento. In futuro, non dovrebbe esserci dolore e i pazienti proveranno una sensazione di sollievo, poiché dopo la procedura la pesantezza, che spesso si osserva nella prostatite cronica, scompare.
Esistono dispositivi speciali che sostituiscono il massaggio rettale della ghiandola prostatica. Il miglioramento della microcircolazione, l'attenuazione di gonfiori e ristagni è assicurato dall'azione delle onde acustiche. Il sensore di tale dispositivo agisce attraverso la pelle, quindi non è necessario l'inserimento di un massaggiatore nel retto. Tali dispositivi possono essere acquistati presso negozi medici speciali. Dovresti prima consultare un urologo e anche studiare le istruzioni.
I massaggiatori possono essere utilizzati a scopo preventivo; la durata del corso delle procedure è determinata dal medico.
Qualsiasi trattamento prescritto da un urologo deve essere accompagnato da una corretta alimentazione e dall'astinenza dall'alcol. È importante ricordare che l'ipotermia può portare ad un'esacerbazione della malattia.























